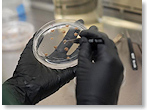

| PEOPLE |
 |
 Walz's Trump-Loving
Relatives Troll Him Walz's Trump-Loving
Relatives Troll Him
Many of them work at the Billy
Carter/Roger Clinton Library. |
|
 |
 Dick Cheney
Says He's Voting for Harris Dick Cheney
Says He's Voting for Harris
Added to his daughter Liz's vote,
Wyoming's suddenly in play for Harris. |
|
 |
Report: Trump Brings
in Tulsi Gabbard to Play
Harris in Debate Prep
“Because they're both sevens,”
he explains. |
| |
| CRIME |
 |
Trump Pleads Not Guilty
to New Jan 6 Indictments
“Wasn't in Washington that day,”
he tells judge. |
| |
| BUSINESS |
 |
Trump Says He'll Have Musk's
“Efficiency Commission” Audit
Federal Spending
“But I can't wait to fire him,”
he confides. |
|
| CONSUMER NEWS |
 |
Researchers
Developing Lab-Grown Chocolate Researchers
Developing Lab-Grown Chocolate
Hey, break me off a piece of that Petri dish. |
|
 |
 Heinz Introduces
Spaghetti Carbonara in a Can Heinz Introduces
Spaghetti Carbonara in a Can
“For the hobo with expensive
taste,” says Heinz. |
|
| |
| HEALTH / MEDICINE |
 |
Study: Placebos Reduce
Stress, Anxiety Even When
You Know They're Placebos
Ask an actor who plays a doctor on TV
if placebos are right for you. |
| |
| CORRECTION |
| |
 Last week we reviewed Mickey's Lost
Weekend, a remake of the 1945 film,
Lost Weekend, about a writer who
thought he quit drinking but falls
off the wagon, then goes on a
three-day bender, with Mickey Mouse
in the role originally played by
Ray Milland. We credited the film
to Disney, which says it had no
part in it. Our apologies for the
error. Last week we reviewed Mickey's Lost
Weekend, a remake of the 1945 film,
Lost Weekend, about a writer who
thought he quit drinking but falls
off the wagon, then goes on a
three-day bender, with Mickey Mouse
in the role originally played by
Ray Milland. We credited the film
to Disney, which says it had no
part in it. Our apologies for the
error. |
|
|

